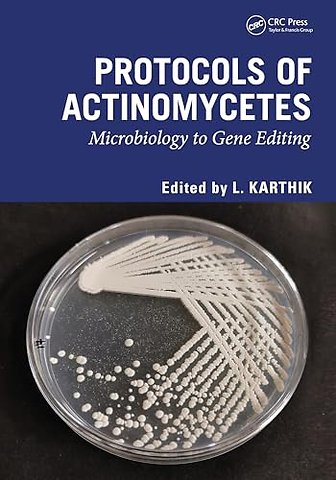

Protocols of Actinomycetes
Microbiology to Gene editing
Samenvatting
This book will cover basics to recent protocols for drug discovery from actinobacteria. It will be helpful for the pharmaceutical industries and researchers to develop new antibiotics from actinobacteria and would be used in support of future research in drug discovery.